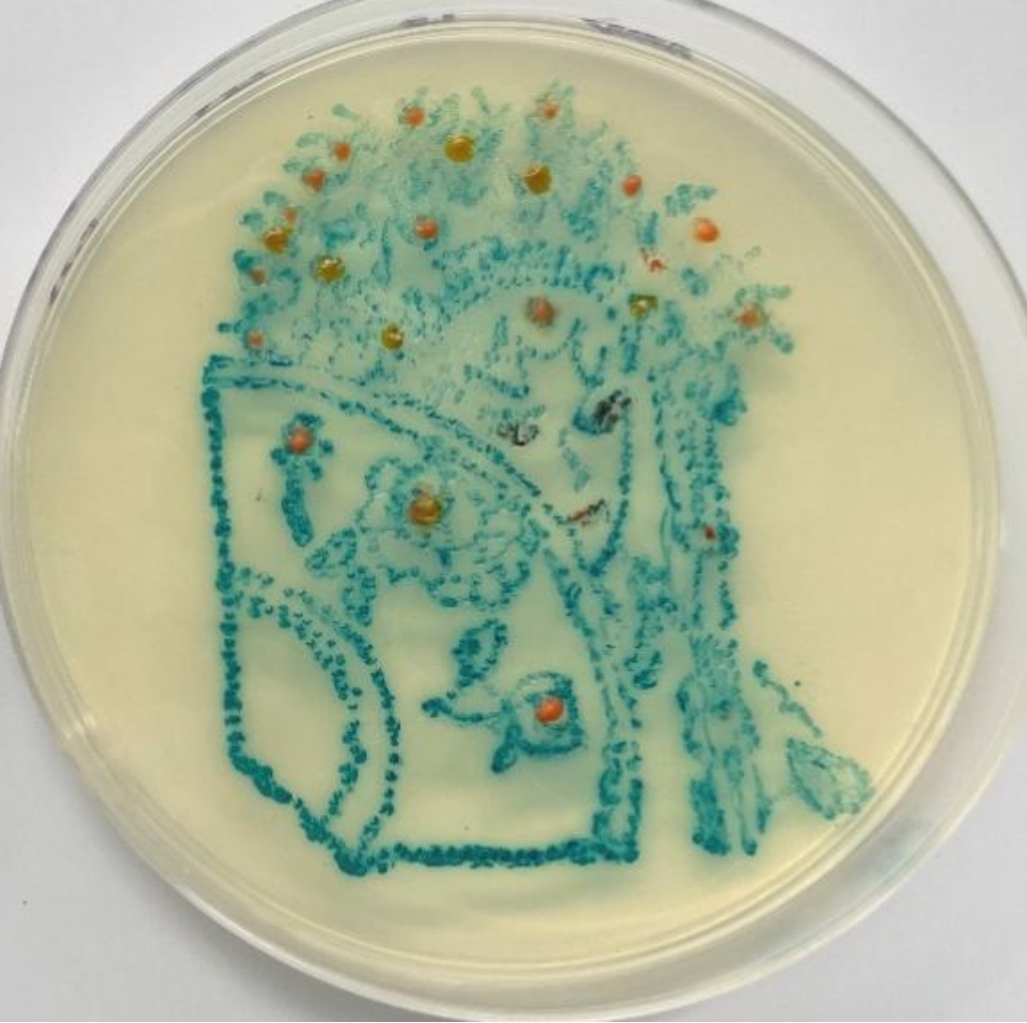
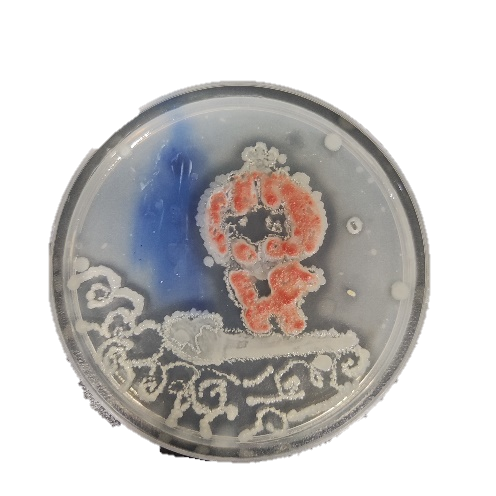
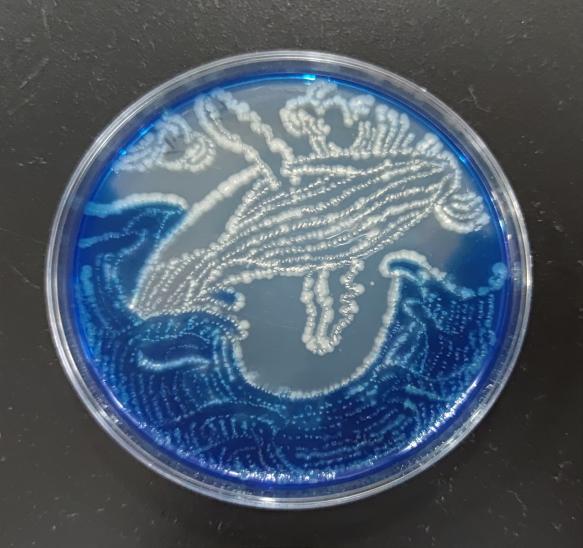
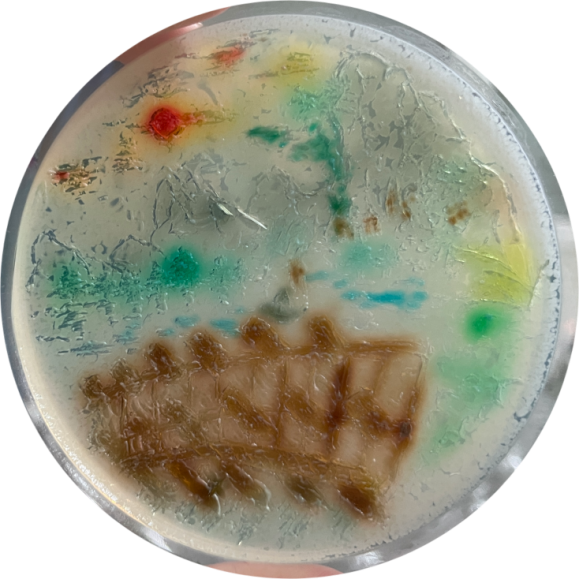
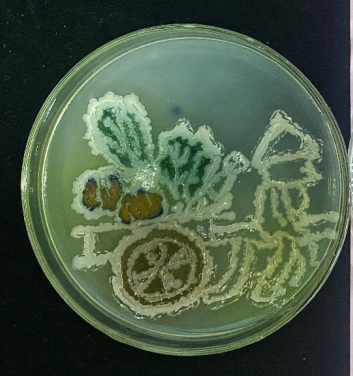

发布时间:2022-07-12 浏览量: 作者: 来源: 生物工程学院
为迎接党的二十大胜利召开、进一步进行爱党爱国爱社会主义教育,激励全国高校师生攻坚克难、开拓奋进,进一步浓厚学校创新创业氛围,推动微生物科学知识普及,拓展同学们的视野,提高动手实践能力、科学探索能力,天津科技大学生物工程学院联合天津市大中小学思政课一体化教学研究联盟、北京工商大学、河北工业大学于6月至7月联合举办了京津冀高校微生物培养皿大赛。
7月4日,2022年京津冀高校微生物培养皿大赛暨“青春献礼二十大,强国有我新征程”之第七届天津科技大学微世界艺术大赛决赛在线上举行。丹娜(天津)生物股份科技有限公司、天津市大中小学思政课一体化教学联盟、天津市滨海新区实验中学、北京工商大学、河北工业大学、天津科技大学马克思主义学院、天津科技大学生物工程学院负责同志、微生物学专业课教师代表出席比赛并担任评委。
经大赛组委会宣讲、往届优秀选手分享经验、创作技能和经验指导、学生积极报名,本届大赛共有64组同学报名,提交作品109幅,初赛作品分为红旅赛道、艺术赛道、天津市大中小学思政课一体化教学研究联盟赛道。经专家评审,共有37组作品进入决赛。37组同学从作品名称、创作理念、实验过程记录及心得体会等方面分享参赛的所感所获。红旅赛道的作品紧扣“青春献礼二十大,强国有我新征程”主题,同学们结合时政,作品中有喜迎二十大、有建团百年、有童心向党、有冬季奥运、有国泰民安。艺术赛道的作品中有代表虎年虎虎生威的的不亦乐“虎”、有可爱憨厚的冰墩墩、有祖国的恬静山水、有星辰大海、有京剧画像。天津市大中小学思政课一体化教学研究联盟赛道的作品中有中国航天梦、有嫦娥奔月、有红领巾、有抗击疫情的“大白”。一幅幅细致精彩的作品赢得评委和观众们的赞叹。
会上,丹娜生物股份科技有限公司副经理盛长忠、天津市大中小学思政课一体化教学联盟秘书长、马克思主义学院院长朱新华、天津市滨海新区实验中学校长董彦旭、生物工程学院党委书记黄学锋致辞,肯定了本次比赛的深远意义,表示用微生物作画是科学与艺术融合的体现,特别是今年联合了天津市的大中小学对科学普及工作具有巨大的推动意义,祝愿赛事越办越好,不断扩大社会影响,为微生物科学的普及教育作出更大的贡献。
生物工程学院党委副书记、院长罗学刚表示,天津科技大学微世界大赛举办七年以来,通过拓宽思路寻突破,创新求变促发展,首次实现了京津冀高校校际联合、校企联合和天津市大中小学的代际联合,是对推进微生物科学普及推广进行的一次新尝试。罗院长对参赛队伍用微生物展示的多彩斑斓的微生物世界表示高度赞赏,认为同学们用科学的精神去探索,用艺术的笔触去描绘,实现了科学与艺术完美结合,体现了同学们对专业的理解和热爱,对美学的追求。微世界艺术大赛是艺术和美的融合,是专业素养的展示、是德智体美劳五育并行的体现,是课程思政实践育人落地的声音。
青春献礼二十大,强国有我新征程。当微小生物遇上家国情怀,微生物的细微之美与家国的宏伟之美迸发出了独特的魅力!同学们以微生物为原料,以移液器为画笔,以培养皿为画卷,奇思妙想勾勒出一幅幅艺术作品,用专业知识和艺术魅力的融合献礼二十大。
斑斓绚丽的微生物世界,我们明年再见!
红旅赛道
特等奖
为实现中华民族伟大复兴、建设现代化强国,我们要不负时代,不负韶华。我们要继续弘扬光荣传统,赓续红色血脉,以实际行动践行“请党放心,强国有我”的青春誓言。

一等奖
鹤鸣九皋,声闻于天!晨光熹微,岁月静好!

“凤凰于飞,翙翙其羽,远去无痕迹。”两凤凰挥动着带有华丽羽毛的翅膀飞向空中,渐渐消失在云中。表示繁荣、吉祥、如意,寓意着美好的未来。寓意着当下”喜迎二十大“国泰民安的景象。

二等奖
“国之交在于民相亲,民相亲在于心相通。”

你们是祖国边防线闪亮的眼睛,你们一伸手就能摘下天上的繁星,你们是军旗上最明亮的星。

“哪有什么岁月静好,不过是有人为我们负重前行”一百年来,一代又一代的中国青年前赴后继,将青春奋斗融入党和人民事业。

担负时代重任,书写灿烂无悔的青春,以青春力量去创造更好、更强、更美丽的未来中国。

三等奖
红船之上回望百年驶向未来,我们初心如磐,我们根脉不忘。乘着新时代大船,奋力谱写壮美华章!

红星照耀中国,与党共迎二十大。新中国成立以来,共产党为人民奉献自己伟大而质朴的力量,带领我们建立更强大的国家与社会。

吻在星⾠浩瀚中,千年梦想正相拥。

“有三岁之翁,有百岁之童”,决定精神面貌的,从来不是时间长短,而是使命的力量。

建党百年历史条件下开启全面建设社会主义现代化国家新征程、在新时代坚持和发展中国特色社会主义,同时坚定道路自信、文化自信,顽强奋斗,推进党的自我革命、提高全党斗争本领和应对风险挑战能力、永葆党的生机活力、团结带领全国各族人民为实现中华民族伟大复兴的中国梦而继续奋斗。

新青年生在红旗下,长在春风里。

青年生逢盛世当不负盛世,我们于春风中,感慨国之强盛,我们于国旗下,培育家国情怀,我们于党旗下,以青春献礼祖国。

党徽当空,青年当下,旗帜飘扬,五谷丰登。

艺术赛道
特等奖
鲸歌中,一鲸落,万物生。鲸鱼落海,凄美却也宛若一曲壮歌。庞大的生命逝去,却象征着更多生命的蓬勃。

一等奖
京剧是中国传统艺术宝库内的一颗明珠,是我国国粹之一,作为年轻一代,我们应该继承和发扬优秀传统文化,将国粹——京剧,发扬光大。
祖国的发展蒸蒸日上,即使面临挫折依然保持活力,积极阳光的态度促进着祖国的繁荣富强。

二等奖
虎,神兽也。吊睛双目,九州威慑震华夏;利爪疾击,大掌似扇急如风;纵跃涧岗,横渡阔江,长啸一声,百兽遁形避无踪。
反观当下。风姿绰约,笑意相迎悦相送;顾盼神飞,虎虎生威亦玲珑;适逢丰收,满载欢愉,不亦乐“虎”,喜唤飞燕恰风生。

少年的征途是星辰大海,并非尘烟人间。

“鱼杏相依“取谐音”余生相依“。体现着自然界的物质循环,除了图案外落款了一个”安“字。

红日照青山,我国山水从古至今名流天下,更应源远流长,我也为祖国拥有的大好河山而自豪。

三等奖
“少年负壮气,奋烈自有时”

在艰难环境下,仍奋力拼搏,不畏艰难
一鲸落,万物生。鲸鱼来时浩浩荡荡,走时除了骨骸不留一点存在过的痕迹。当它深知自己临近生命的终点,便一跃而起,陨落于海洋,以自己之躯供万物生长。
精神是一个人的立身之本。精神不灭,灵魂永存。不畏困难,无惧牺牲。

2008,2022代表北京举办奥运会的年份,五环代表奥林匹克精神永不落幕。

滔滔不绝的江河和巍峨的山脉代表着中华民族五千年的历史,代表着强大的中国,坚实的桥梁代表着中国人民脚踏实地精神。
收获正是农民最大的愿望。
孔子说:“逝者如斯夫,不舍昼夜。”愿我们都能向阳生长,逆风而上,携一身轻盈向阳绽放!

天津市大中小学思政课一体化教学研究联盟赛道
特等奖
“百年大党书写恢弘史诗。”将航天梦和中国梦紧密联系在一起,以实际行动诠释了爱国主义精神,成为中国人民勇攀高峰的真实写照!

一等奖
党从建立伊始的红船不断发展壮大,不惧风浪、扬帆远航,我国的技术革命发展齐头并进,不断突破、不断创新,在党的领导下国泰民安,富强和谐,是国家的福祉,是人民的支柱。

“清澈的爱,只为中国”在党的团结带领下,爱国情怀深深影响着一代又一代的有志青年。

二等奖
嫦娥是古代神话中人们用来探寻月球的方式 ,因此有古今结合的意味,从古至今人们对月球的追寻从未停下脚步 。当下中国,国力日益强盛,人民安居乐业,对于航天事业的发展仍在继续。

身穿防护服的大白化身战士,手拿红旗,在蓝天白云下,背靠太阳。有这群勇敢的人来保护我们,我们始终坚信阳光总在风雨后,疫情终将散去。

红领巾飘扬在蔚蓝的海浪上,金黄色的五角星镶嵌在其中,将少年的爱国情怀体现得淋漓尽致。

深受党和中国精神影响的当代青年,展现着青年人渴望为中国共产党的发展奉献自己的力量,青春献礼二十大,中国青年一定会心怀远大抱负,为党为国家的发展而奋斗。
